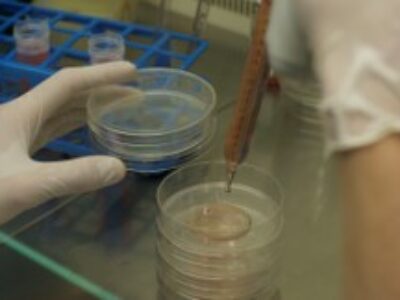

Récolter des algues nécessite de trouver des entreprises ayant besoin de cette matière première pour la transformer et la valoriser. Au cours du projet ENTEROMORPHES, cette thématique était l’objet d’études de deux partenaires. ALGAIA, avec son laboratoire de recherche et développement basé à Saint Lô, a cherché à extraire les molécules spécifiques des algues vertes ayant un potentiel économique. Le but était déjà de déterminer les axes de valorisation pour cette algue. ACTALIA, de son côté, a étudié la possibilité d’intégrer l’entéromorphe dans des produits alimentaires en valorisant sa richesse en magnésium, élément reconnu comme un anti-fatigue.
Les entéromorphes vont devenir des algues récoltables en Normandie.
Les entéromorphes, algues vertes de genre Ulva, sont présentes au printemps et en début d’été sur les poches à huîtres. L’évaluation faite au cours de ces deux dernières années a permis de voir que cette ressource était exploitable entre les mois de mai et juillet (cf. article du 22 décembre 2018). Le schéma des structures est actuellement en cours de révision pour qu’à l’avenir, un ostréiculteur puisse demander auprès de la Direction Départementale des Territoires et de la Mer l’autorisation d’exploiter ces algues sur ses concessions. Toutefois, si la récolte est possible, il fallait évaluer les possibilités de commercialisation de ces algues. Pour cela, deux voies de valorisation ont été explorées : l’extraction de molécules d’intérêt d’une part et l’intégration de ces algues dans des produits alimentaires d’autre part.
L’extraction de molécules actives spécifiques des algues vertes.
En un premier temps, il fallait connaitre les principaux éléments qui composent les algues. Après diverses analyses, il s’avère que les entéromorphes contiennent majoritairement des sucres et notamment des Ulvanes (sucres spécifiques des algues vertes). Ces sucres sont connus pour leur activité antivirale. Toutefois, leur teneur varie en fonction des sites et des années et un suivi régulier permettrait de déterminer la teneur minimale sur laquelle un industriel peut élaborer une stratégie économique.
En un deuxième temps, des tests ont permis de définir une méthode d’extraction de ces molécules à moyenne échelle. Cependant, des tests supplémentaires devront optimiser la conservation des extraits. Des tests de bioactivité ont été réalisés à partir de ces extraits. Sur la bioactivité antivirale, les essais réalisés ont donné des résultats très encourageants même si des voies d’améliorations doivent être encore explorées. Concernant l’effet biostimulant, les premiers tests effectués sur des salades n’ont pas encore donné de résultats probants par contre, au cours de ces tests, il a été démontré un effet nutrition (sur base azote) sur ces cultures Cependant, tous ces résultats restent à confirmer à l’avenir.
Des algues riches contre la fatigue.
Ulva sp. est une algue inscrite comme algue alimentaire, il semblait intéressant d’explorer cette voie : Proposer des concepts de produits alimentaires innovants permettant de valoriser les entéromorphes récoltées, voici le challenge confié à ACTALIA Innovation.
Une étude de la bibliographie a permis de mettre en évidence que l’entéromorphe était une algue très riche en magnésium (autour de 2000 mg / 100g). Les analyses effectuées ont confirmé ces résultats. Le magnésium est considéré comme un anti fatigue et reste indispensable à l’équilibre alimentaire. Or, il est estimé que l’apport nutritionnel moyen est de 20% en deçà de l’apport conseillé.
A partir de ce constat, une étude de marché consistant à analyser l’offre alimentaire actuelle et les attentes des consommateurs a permis de confirmer l’intérêt de proposer une nouvelle solution alimentaire:
- « plaisir » pour prévenir le manque d’énergie, se rebooster et retrouver son équilibre de façon naturelle et efficace.
- originale et innovante car pratique et facile à consommer
Suite à cela, des ateliers de créativité, animés par ACTALIA, intégrant leur triptyque marketing, design et recherche & développement, ainsi que les acteurs du projet, scientifiques comme ostréiculteurs ont permis de générer les 3 concepts suivants :
- Ma Pause Vitalité : mini snacks salés ou sucrés pour compléter l’apport journalier en magnésium
- Boost n’ Break : biscuit nourrissant et complet pour les sportifs
- The Good Green : Smoothie 100% végétal pour un encas sain et énergisant
Tous ces aliments répondent aux allégations de santé fonctionnelle dans la contribution à réduire la fatigue.
L’ensemble de ces travaux démontre de vraies voies de valorisation de l’entéromorphe en Normandie. Cependant des travaux complémentaires sont indispensables que ce soit pour des débouchés biochimiques ou alimentaires et apporter aux ostréiculteurs normands la possibilité de diversifier leur activité avec une ressource présente sur leurs parcs.
Partenariat technique.
Partenariat financier.